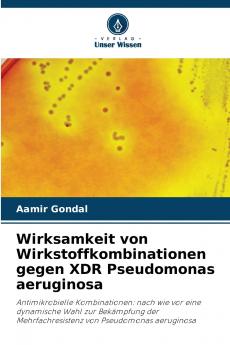
Wirksamkeit von Wirkstoffkombinationen gegen XDR Pseudomonas aeruginosa

German
Paperback
₹4619
₹6077
23.99% OFF
(All inclusive*)
Delivery Options
Please enter pincode to check delivery time.
*COD & Shipping Charges may apply on certain items.
Review final details at checkout.
Looking to place a bulk order? SUBMIT DETAILS
About The Book
Description
Author
Die sich ständig verändernde Welt der Mikroben stellt die Menschheit vor immer neue Herausforderungen. Die derzeitige Bedrohung durch Mehrfachresistenzen macht das bilaterale Zusammenleben noch kostspieliger und komplizierter. Noch schlimmer ist die reibungslose Ausbreitung dieser Resistenz über Kontinente hinweg aufgrund der leichten Mobilität der Menschen in der globalen Welt. Die Idee der Kombination von Antibiotika wurde genutzt um die schädlichen Auswirkungen dieser Resistenz zu verlangsamen und zu begrenzen. Pseudomonas-Arten die maßgeblich zu nosokomialen Infektionen beitragen reagieren offenbar auf die Kombinationstherapie. Das Ausmaß der Bedrohung erfordert jedoch dass alle möglichen Wege geprüft und beschritten werden. Die hoffnungsvollen Ergebnisse dieses Projekts und die Feinheiten des Gleichgewichts zwischen Mensch und Mikroben halten den Kampf zwischen den Parteien jedoch offen. Die Leser dieses Buches werden es interessant finden dass manchmal ein kleiner Durchbruch sehr wertvoll ist und die Motivation aufrechterhält. Noch faszinierender ist die Tatsache dass Medikamente nur ein Aspekt im Kampf gegen diese Resistenz sind und dass kulturelle und soziale Veränderungen eine entscheidende Rolle spielen werden.
Delivery Options
Please enter pincode to check delivery time.
*COD & Shipping Charges may apply on certain items.
Review final details at checkout.
Details
ISBN 13
9786206805533
Publication Date
-30-04-2025
Pages
-72
Weight
-111 grams
Dimensions
-152x229x4.38 mm